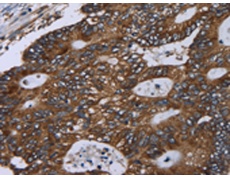
一抗

|
Background: |
The Golgi apparatus, which participates in glycosylation and transport of proteins and lipids in the secretory pathway, consists of a series of stacked cisternae (flattened membrane sacs). Interactions between the Golgi and microtubules are thought to be important for the reorganization of the Golgi after it fragments during mitosis. This gene encodes one of the golgins, a family of proteins localized to the Golgi. This encoded protein has been postulated to play roles in the stacking of Golgi cisternae and in vesicular transport. Several alternatively spliced transcript variants of this gene have been described, but the full-length nature of these variants has not been determined. |
|
Applications: |
ELISA, WB, IHC |
|
Name of antibody: |
GOLGA2 |
|
Immunogen: |
Fusion protein of human GOLGA2 |
|
Full name: |
golgin A2 |
|
Synonyms: |
GM130 |
|
SwissProt: |
Q08379 |
|
ELISA Recommended dilution: |
2000-5000 |
|
IHC positive control: |
Human colon cancer and human liver cancer |
|
IHC Recommend dilution: |
100-300 |
|
WB Predicted band size: |
113 kDa |
|
WB Positive control: |
293T, Hela, A172 and A549 cells |
|
WB Recommended dilution: |
500-2000 |


 購物車
購物車 幫助
幫助
 021-54845833/15800441009
021-54845833/15800441009